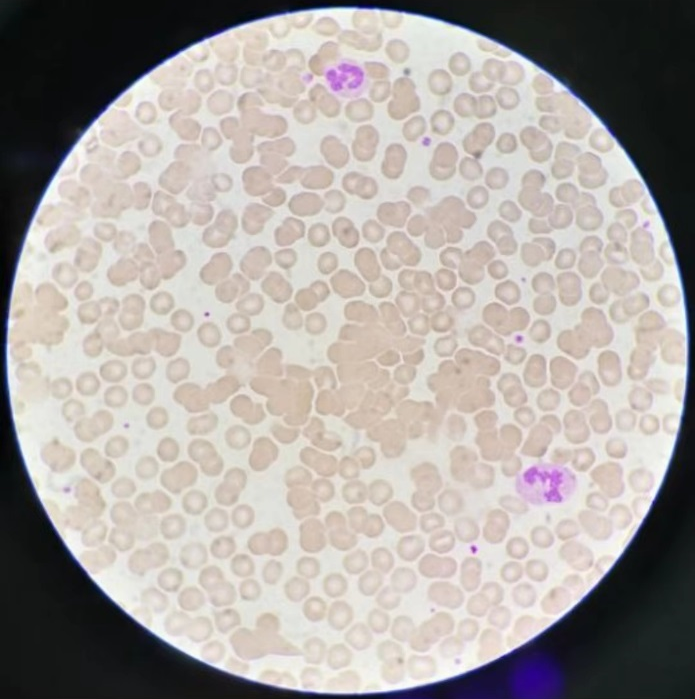

一例冷凝集素病患案例及常规解决方法
案例经过:

红细胞计数与血红蛋白比例严重偏离1:30,红细胞计数(2.87×1012 g/L)明显减少(参考范围:4.2-5.7×1012 g/L),HCT(27.1%)明显减低(参考范围:36%-46%),MCV:94.4fl(82-100)在正常参考范围内,而MCH: 45.6pg(27-34),MCHC:483g/L(316-354)均明显高于参考范围上限,结果明显相互矛盾。再看标本无明显异常(未见管壁上有明显凝集颗粒)。
查看患者红细胞直方图,明显有一群大细胞群(如下图二:孵育前红细胞直方图),

图二:孵育前红细胞直方图
解决:
更加确定了有红细胞凝集干扰,取少量标本推片镜下观察,再将标本放入37℃温箱孵育,镜下涂片如下图三:红细胞瑞吉染色,可明显见到聚集成团的红细胞。
图三:红细胞瑞吉染色
孵育后标本混匀立即上机检测,结果如下图四:孵育后结果

图四:孵育后结果
可见结果均恢复正常,红细胞与血红蛋白比例正常,MCV:84fl(82-100), MCH:28.1pg (27-34),MCHC:335g/l(316-354)均恢复正常,红细胞直方图翘尾部分消失,证实了怀疑,即为红细胞凝集导致红细胞相关结果异常。

图五:孵育后红细胞直方图
查询患者病历:男,9岁5月,初步诊断:肺炎支原体肺炎,EB病毒抗体定量:EB病毒衣壳抗原IgM抗体 79.10U/ml,EB病毒衣壳抗原IgG抗体 156.00U/ml,EB病毒核心抗原IgG抗体 >600.00U/ml。提示EB病毒感染。因此病人可能为支原体合并EB病毒感染导致冷凝集素产生,使红细胞凝集。经过温浴后结果恢复正常。
【 知 识 回 顾 】
红细胞与血红蛋白数量间有大致比例关系:1:30,一般遵循此比例,若比例异常应注意查找原因,关注HCT、MCV MCHC MCH结果,综合判断,最快捷方法是看一下仪器散点图是否异常。
冷凝集素病发病机制
冷凝激素是一种IgM型自身抗体,多数针对红细胞表面的i抗原和I抗原,少数针对Pr抗原。出生后i抗原慢慢转换为I抗原,因此成人红细胞上都是I抗原,而无i抗原。支原体肺炎感染相关的冷凝激素具有抗I特异性,传染性单核细胞增多症相关的冷凝激素具有抗i特异性。
冷凝激素病可导致红细胞的破坏,发生的机制为IgM抗体有固定补体的能力,其有两个C1q的结合位点,在低温时可与红细胞膜上的抗原相结合,发生冷凝集,但此凝集是可逆的,温度恢复37℃时,凝集的红细胞与冷凝激素分离,红细胞也再次分开,细胞表面保留了C3片段,后者能结合C1与免疫球蛋白重链Fc段,经过经典的补体活化途径,引起红细胞溶血发生,但该过程发生的强度依赖于红细胞表面冷凝激素的数量、以及激活补体途径的能力。因此并非所有体内有冷凝激素的患者均发生明显血管内溶血。
临床表现
高亲和力冷凝激素遇冷可使红细胞在毛细管循环中大量凝集,手足发绀,发生血管内溶血,出现血红蛋白尿,此种冷凝集抗体可见于支原体感染、肺炎链球菌感染、继发于病毒(EBV)感染、肝脏疾病、淋巴系统肿瘤、经常输血等患者。
实验室检查
本科室血常规检测仪器为希森美康XN3000系列,采用鞘流阻抗法检测红细胞,当存在冷凝集现象时,RBC凝集,凝集的红细胞团被误认为成一个红细胞,导致MCV增高,RBC计数减低,HCT减低,由于红细胞本身为双凹圆盘状,若红细胞聚集成团,则其较单独红细胞体积之和小,再与减少的红细胞个数相乘积,得到最终HCT明显减小。由于血红蛋白为溶血后检测,故其不受影响,但由于RBC计数假性减低,故与其相关的MCH、MCHC结果受影响严重。
总结
血常规检测是实验室最基本的检测项目,如果遇到红细胞参数异常,相互矛盾,一定要引起注意,查找原因。冷凝集标本常容易被忽视,冬季天气较冷、夏季实验室空调打开均容易出现冷凝集现象,在审核血常规报告中,应注意检验结果之间相互关系、仪器散点图及报警信息,重视血液图片镜检,以保证检验质量。
文章作者:袁孟伟 承德医学院附属医院
编辑:伟


